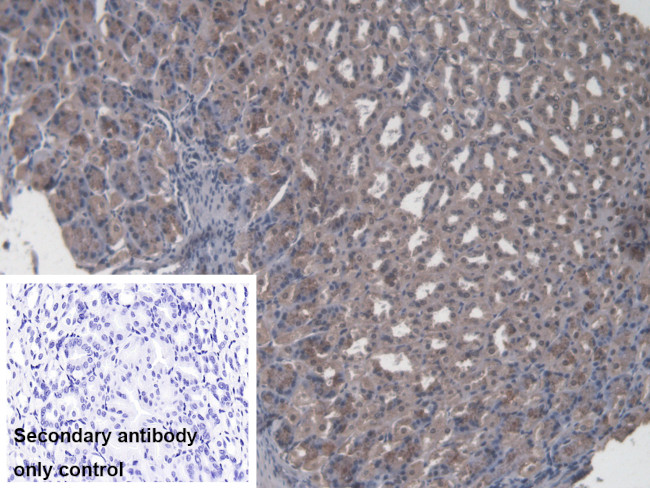
CBF beta Antibody in Immunohistochemistry (Paraffin) (IHC (P))

Search
Invitrogen
CBF beta Polyclonal Antibody
{{$productOrderCtrl.translations['antibody.pdp.commerceCard.promotion.promotions']}}
{{$productOrderCtrl.translations['antibody.pdp.commerceCard.promotion.viewpromo']}}
{{$productOrderCtrl.translations['antibody.pdp.commerceCard.promotion.promocode']}}: {{promo.promoCode}} {{promo.promoTitle}} {{promo.promoDescription}}. {{$productOrderCtrl.translations['antibody.pdp.commerceCard.promotion.learnmore']}}
图: 1 / 6
CBF beta Antibody (PA5-119052) in IHC (P)






Please note: We are reviewing Western blot images included in the antibody testing data in our catalog, including those provided by third parties. Unless expressly labeled or annotated as “raw-unedited”, Western blot images included in the antibody testing data in our catalog may have been edited, optimized or otherwise adjusted for presentation.
产品信息
PA5-119052
种属反应
宿主/亚型
分类
类型
抗原
偶联物
形式
浓度
规格
纯化类型
保存液
内含物
保存条件
运输条件
RRID
靶标信息
The protein encoded by this gene is the beta subunit of a heterodimeric core-binding transcription factor belonging to the PEBP2/CBF transcription factor family which master-regulates a host of genes specific to hematopoiesis (e.g., RUNX1) and osteogenesis (e.g., RUNX2). The beta subunit is a non-DNA binding regulatory subunit; it allosterically enhances DNA binding by alpha subunit as the complex binds to the core site of various enhancers and promoters, including murine leukemia virus, polyomavirus enhancer, T-cell receptor enhancers and GM-CSF promoters. Alternative splicing generates two mRNA variants, each encoding a distinct carboxyl terminus. In some cases, a pericentric inversion of chromosome 16 [inv(16)(p13q22)] produces a chimeric transcript consisting of the N terminus of core-binding factor beta in a fusion with the C-terminal portion of the smooth muscle myosin heavy chain 11. This chromosomal rearrangement is associated with acute myeloid leukemia of the M4Eo subtype. Two transcript variants encoding different isoforms have been found for this gene.
仅用于科研。不用于诊断过程。未经明确授权不得转售。
篇参考文献 (0)
生物信息学
蛋白别名: CBF-beta; Core-binding factor subunit beta; PEA2-beta; PEBP2-beta; Polyomavirus enhancer-binding protein 2 beta subunit; SL3-3 enhancer factor 1 subunit beta; SL3/AKV core-binding factor beta subunit
基因别名: AI893578; CBFB; PEA2; Pebp2; PEBP2b; Pebpb2
UniProt ID: (Mouse) Q08024
Entrez Gene ID: (Mouse) 12400